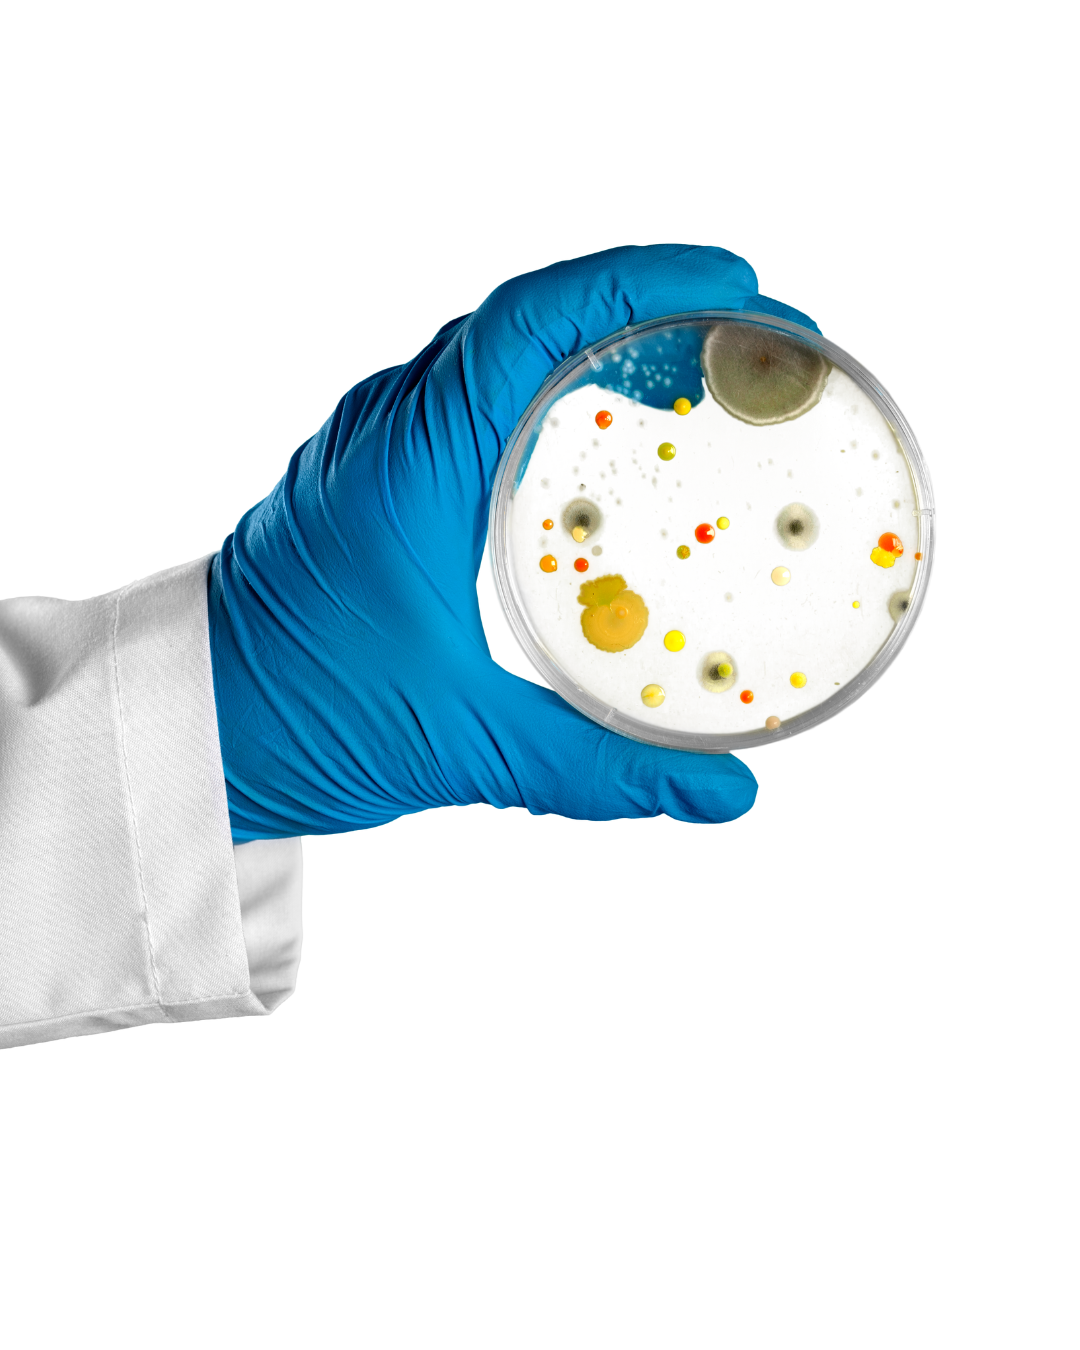

AS SEEN IN

“I noticed a difference in just a week! My bloating went down and my skin started clearing up. These probiotics actually do something.”

“Finally found a probiotic that doesn’t upset my stomach. I take it every morning with my coffee and feel lighter and more balanced all day.”

“This is now part of my daily routine. My digestion feels smoother, and I haven’t been sick all season. Worth every penny!”

FAQ
Get excited for an unboxing experience. Each CRANEL purchased along with instructions and storage recommendations. Our boxes and inserts are recyclable so do a
favour for mother earth.
We recommend drinking a bottle of CRANEL once a week to keep your health on point. Each shot has 500mg of PACs, the active ingredient that helps flush bacteria. You can drink CRANEL as often as you'd like as it is natural with zero added sugar, one side effect might be glowing skin!
Once you receive your CRANEL pop your bottles in the fridge. When you are ready to drink your CRANEL shake the bottle for 20 seconds.
You can drink CRANEL straight (it's an acquired taste), with a smoothie, or watered down. Drink one per week and recycle your bottles!
We are an Australian-owned business. CRANEL is strictly manufactured in Australia and the US, depending where you purchase from.
We will send you a box of CRANEL each month. You can select the day of delivery when you log into your account!












